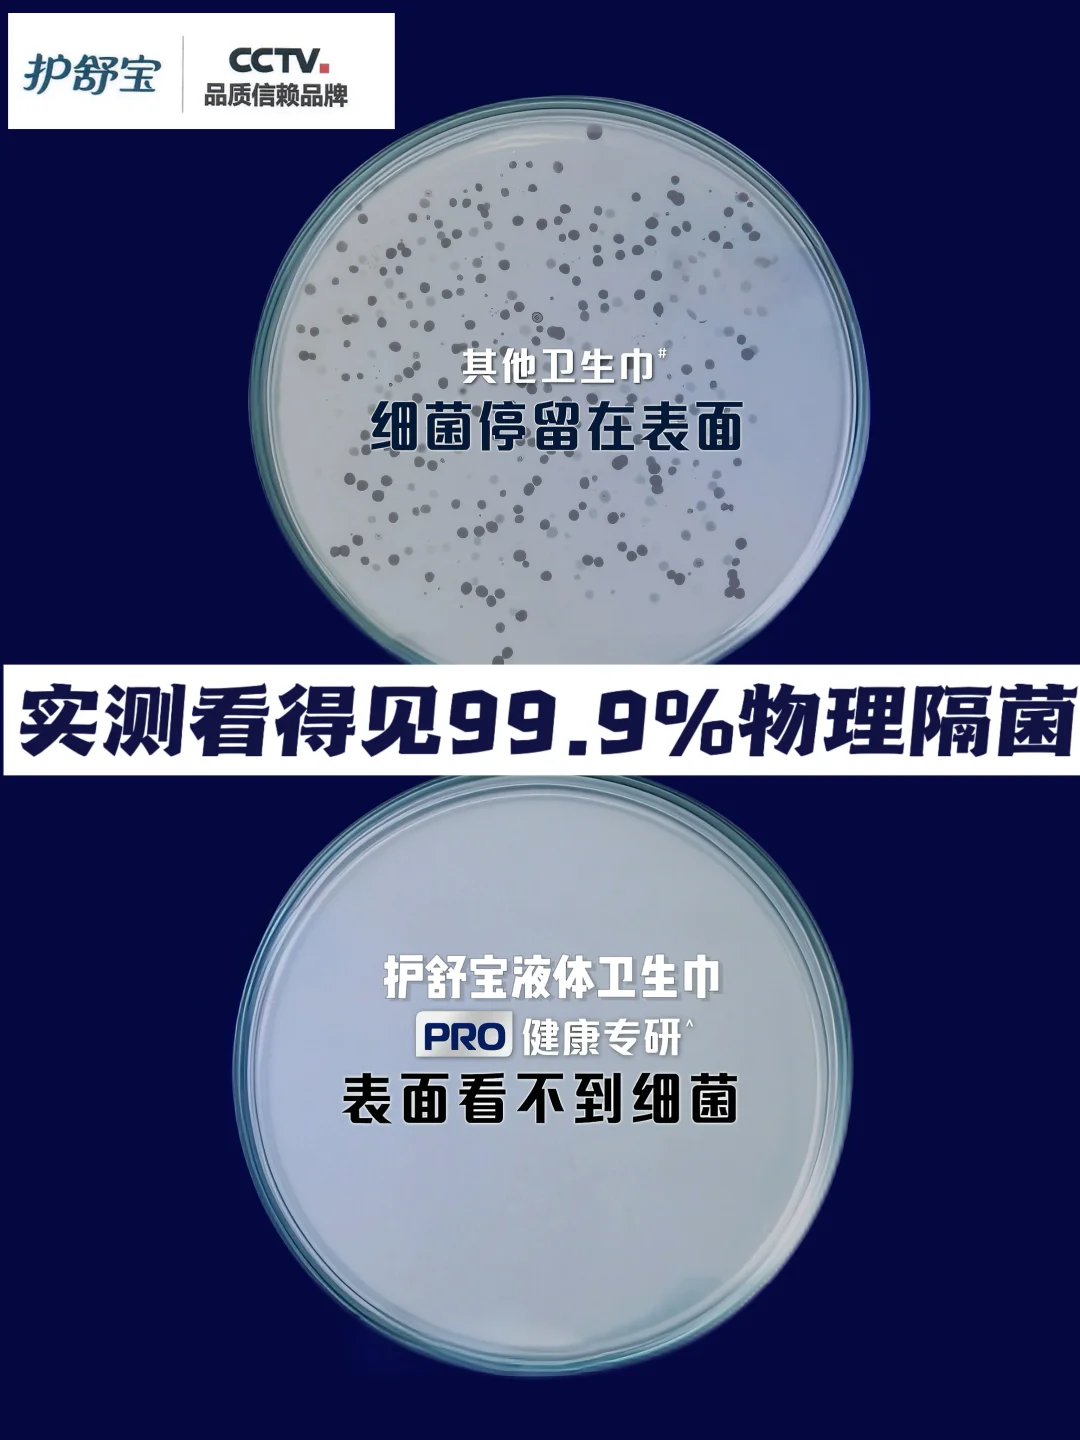

人生建议,体弱之人,真的应该像猫一样生活
通过学习猫咪的一些生活习惯和特性
调整自己的状态,拥有自己的步调~
猫咪是很爱干净很讲究的小动物
每天都花大把时间清理自己
因为小猫真的很爱自己
无论发生什么,它都把自己的舒适性放在第一位
人也要这样,自己舒服才是最重要的
平时为了贪点小便宜
超市什么打折就囤什么卫生巾
结果一到经期,特别是量大那两天
每次一坐下就感觉坐在一滩血上
黏黏乎乎的,久了还会发痒!!
后面终于狠下心,想着一个月也就来那么一次,
给自己买个好的!
直接就冲了现在市面的卫生界“爱马仕”
——护舒宝物理隔菌卫生巾[派对R]
才知道每个月多花一杯奶茶的钱
原来可以这么爽!!
99.9%物理隔菌黑科技
不管你月经量多大,都能直接一吸到底!
就像在肌肤上建了个“物理隔菌盾”
隔绝了99.9%的经血和细菌!
就这么薄薄一片的东西
吸完之后也不会膨胀变厚成一大坨,
干爽到老是忘记自己在来月经!
肤感也特好,又亲肤又细腻
一整天都清清爽爽舒舒服服的!
不是……之前在过的都是什么苦日子啊……
奉劝女生们来月经本来就辛苦了,真的要对自己好一点!!
月经护舒宝健康知识科普好用的卫生巾卫生巾推荐护舒宝物理隔菌卫生巾经期健康健康养生秋季养生护舒宝液体卫生巾PRO健康专研物理隔菌卫生巾私护保养推荐私处护理贵妇卫生巾私处痒私处长痘